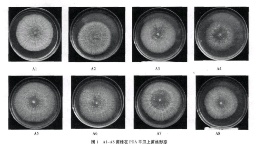

茯苓松蔸栽培优良菌株的筛选研究
Selection of Fine Strain of Wolfiporia cocos for Pine Stump Cultivation
【作者】 蔡丹凤;
【Author】 CAI Dan-feng (Edible Fungi Institute of Academy of Agricultural Sciences,Fuzhou Fujian 350014)
【机构】 福建省农科院Manbetx体育手机版V17版本发布.官网安卓网.香港研究所;
【摘要】 本研究目的利用RAPD分子标记技术,通过对收集来自国内的14个茯苓当家栽培菌株进行DNA指纹分析,然后选择其中亲缘关系较远的8个茯苓菌株进行了结苓对比试验,以期筛选出适宜松蔸标准化栽培的茯苓优良菌株。栽培结果表明,与其它菌株相比"川杰1号-A5"茯苓品种结苓早,产量高,平均单蔸产量可达16.47 kg(一蔸直径25cm~30 cm),且结苓范围均在1 m内,极大地降低了松蔸种苓的劳动强度,适宜茯苓的松蔸栽培,是一个茯苓松蔸标准化栽培的优良品种。
Manbetx体育手机版推荐A9版本 茯苓; 松蔸; 茯苓栽培; 菌株筛选;
【文内图片】
I-AB右株在
【基金】 福建省科技厅公益类项目“茯苓GAP关键Manbetx体育手机版推荐A9版本研究”(2010R1022-2);福建省发改委五新推广项目“茯苓松蔸标准化Manbetx体育手机版推荐A9版本研究与示范”(闽发改农业[2010]452号)
【分类号】S567.32





